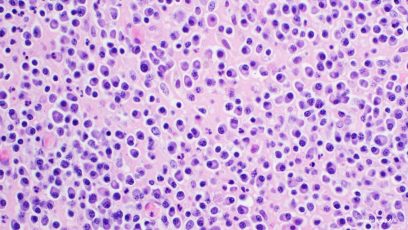

Ida Bruun Kristensen
Ida Bruun Kristensen, MD, PhD, is Consultant at the Department of Hematology, Odense University Hospital, and Chair of the Danish Multiple Myeloma Study Group (DMSG). She specializes in multiple myeloma and actively contributes to research on emerging therapies in the field.